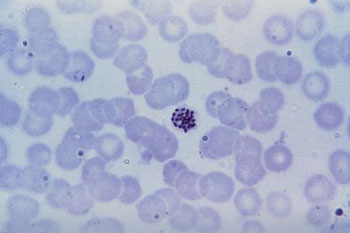
图片A：吉姆萨染色血片中寄生的恶性疟原虫的显微照片（照片由CDC提供）。
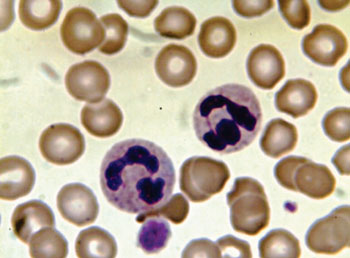
图片B：外周血涂片利什曼氏染色的显微照片（照片由Quazoo提供）。

不同染色法疟疾血片的比较
By LabMedica International staff writers
Posted on 21 Apr 2015
疟疾的早期寄生虫学诊断是疟疾治疗和控制的基石,虽然疟疾的快速诊断检验使用越来越多,但显微镜检查仍是疟疾诊断的标准方法。Posted on 21 Apr 2015
疟疾流行区域使用薄涂片和厚涂片诊断疟疾,但血中元素的检查还能显示其他引起发热的原因,包括白血病,或病毒感染或细菌性败血症的迹象,具体取决于使用的染色技术。
Mahidol University(Bangkok,Thailand)的科研人员在印度的国际团队中工作,检验了2012年8月至12月间在当地医院住院的1180件发热病例的外周血涂片。同时使用10微升乙二胺四乙酸(EDTA)处理的血样制备了两张薄涂片和厚涂片,一张用吉姆萨染色,另一张用利什曼氏染色。
固定后,血涂片用吉姆萨染色(Qualigen;Mumbai,India)或用利什曼氏染色(S D Fine-Chem Ltd.;Mumbai,India)。吉姆萨染色切片和利什曼氏染色切片中,厚涂片用于诊断和定量评估,而薄涂片用于物种鉴定。用两个显微镜分别量化所有疟疾阳性病例每200个白细胞(WBC)的寄生虫血症。
比较1180名发热患者经不同染色法的血涂片,111名患者的血涂片经吉姆萨染色鉴别出寄生虫血症,110名患者的血涂片经利什曼氏染色鉴别出寄生虫血症。有92名患者感染了恶性疟原虫,2名患者感染了间日疟原虫,17名患者感染了这两种寄生虫。共有276名患者有其他异常症状,包括嗜中性粒细胞指标值下降、非典型淋巴细胞、感染性单核细胞征兆,以及1例急性淋巴母细胞性白血病(ALL)。染色方法不同检出寄生虫血症的差异随着寄生虫密度的增大而增高。
作者得出结论,薄涂片和厚涂片利什曼氏染色法(曙红-亚甲蓝溶液染色)是吉姆萨染色的一种优良替代法,用于鉴别疟原虫,且利什曼氏染色法令红细胞和白细胞形态可视化的效果更胜一筹。利什曼氏染色所需的时间较短,这在诊断实验室不足的国家(诸如印度)具有重要的优势。研究已发表于2014年12月30日刊的Malaria Journal(疟疾杂志)。
Related Links:
Mahidol University
Qualigen
S D Fine-Chem Ltd